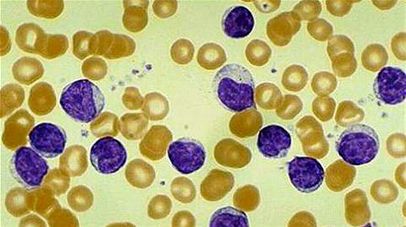

Σε μείωση των τιμών του προχωρά φέτος το Εθνικό Θέατρο, το οποίο καθιερώνει γενική είσοδο 10 ευρώ για παιδιά και ενήλικες στην Παιδική Σκηνή, επεκτείνει την μειωμένη τιμή των 13 ευρώ που ίσχυε κάθε Πέμπτη και στις απογευματινές παραστάσεις της Τετάρτης, διατηρεί τον Μήνα Θεάτρου για νέους με είσοδο 10 ευρώ, μειώνει τις τιμές και […]
Συνέχεια